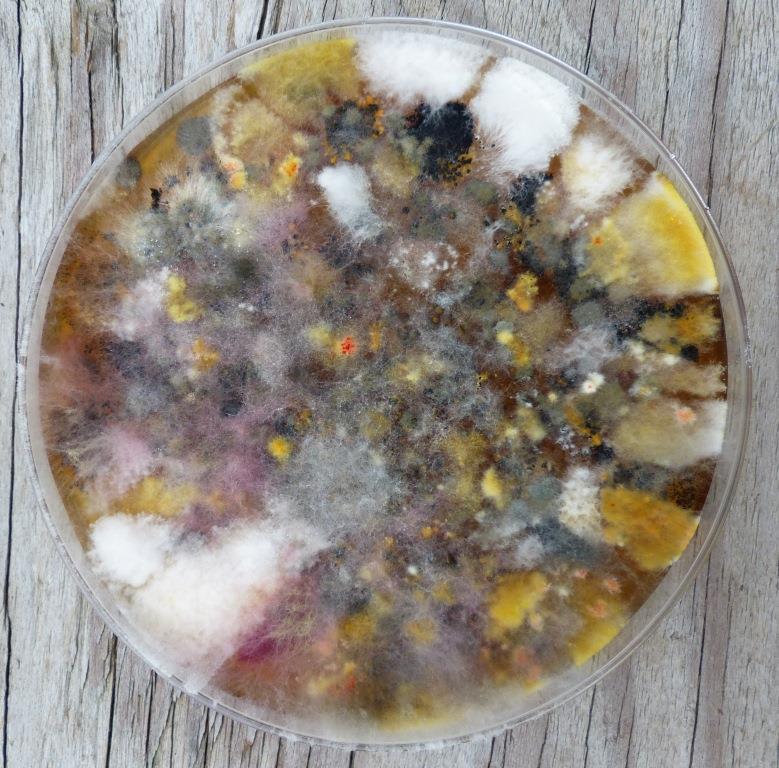
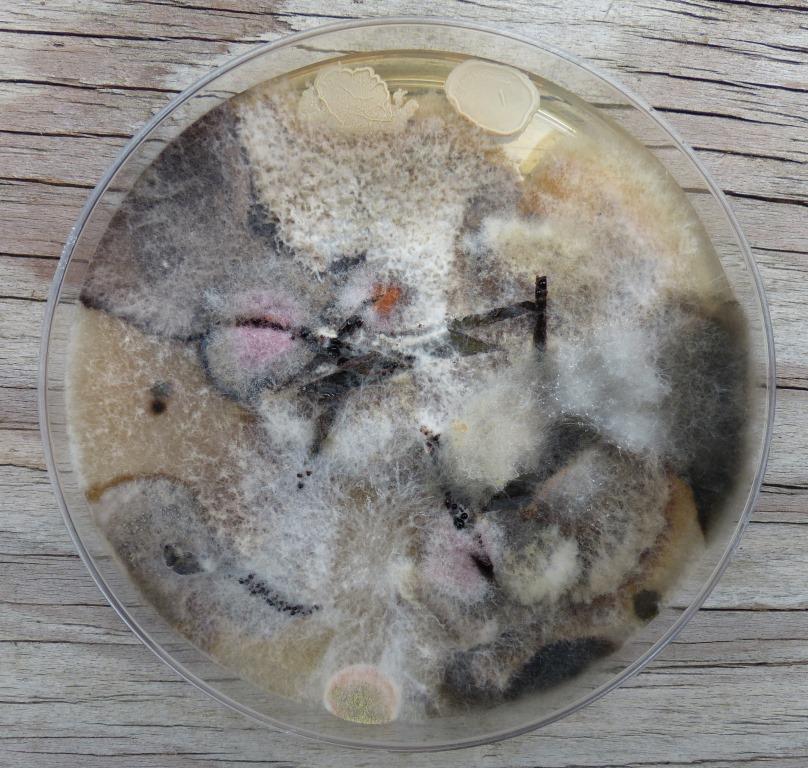
Maple_endo2

I recently had a run-in with some bacterial cousins, courtesy of a small post-surgical wound. The bacteria were winning, so I spent a few days in the hospital where attentive medical staff mainlined antibiotics into my arm. The treatment worked, I’m all healed up, and the hospital guards set me free.
There were some interesting lessons in the wheeled tree of bags and bottles that was my shadow, my daemon, my constant umbilical companion.
The molecules flowing into me were labeled and bar-coded. As was I. Both patient and bag were laser-scanned with every fresh dose of fluid. Just like the supermarket checkout: Beep-beep. And thereby, errors avoided, we hope.
But the names and numbers hid a deeper history. Each one of the antibiotics that I received was a synthetic derivative of a drug derived from a living organism. In other words, scientists took an antibiotic produced by a bacteria or fungus, then synthesized a new molecule that was modeled on the original chemical structure but with some extra added molecular tails and loops. Why bother with the modifications? Sometimes the synthetic version is more potent; sometimes it is a replacement for the original, a replacement necessitated by the evolution of antibiotic resistance in the pathogenic bacteria.
These drugs therefore belong to the second generation of antibiotics. The first generation were derived from other species, mostly from soil bacteria. These eventually lost their effectiveness as evolution did its work. The second generation of antibiotics take the original “scaffolds” or shapes, then tweak them to develop chemicals that are new, but not very different from the originals. This usually means that these second generation antibiotics have a limited lifetime of medical utility. The pathogenic bacteria, having found ways to dodge the first versions take little time to develop resistance to these new, rather similar synthetic versions. For drug companies working to make a profit, this is a bad investment strategy: why invest money and time developing products that will be useless, or nearly so, in the short or medium term? There is much more money to be made in convincing men that they need more testosterone. (The idea that the world might be better with a little less testosterone is unprofitable, it seems.) For the rest of us, none of this is good news. Bacterial evolution threatens to outpace the rate of development of new antibiotics.
I had the latest copy of Nature to keep me entertained during my stay and, by coincidence, it had a great article about a new avenue in drug development, an avenue that also promises to give us some fabulous insights into soil biology. Rather than move further down the path of synthetics, Ling et al., the paper’s authors, returned to the soil. Science’s initial foray into soil antibiotics was able to examine only one percent of the organisms that dwell in the soil. The other ninety nine percent died when brought into the lab. The first generation of antibiotics, in other words, was built on a tiny fraction of the soil’s potential pharmacopeia.
Instead of bringing soil to the lab, Ling’s team brought the lab to the soil. They buried a small “iChip,” a rectangular device filled with tiny bore holes, in the soil. The chip had previously been soaked in a diluted sample of soil. Bacteria colonized the holes and, because they were returned to their habitat in the soil, many of them thrived. Instead of one percent, the researchers managed to culture fifty percent of the soil microbes. Kaboom: That’s one small borehole for a bacteria, one giant leap for humankind.
Once the bacteria colonized and grew in the chip, they were presented with pathogenic bacteria like Staphylococcus aureus (“staph”) or Mycobacterium tuberculosis (“TB”). Using this method, Ling’s group discovered a new antibiotic that they named teixobactin. Importantly, this chemical is not structurally similar to existing antibiotics and the researchers have so far been unable to find any bacteria that can resist its attack. No doubt the same method will yield more drugs as we learn to converse with the mysteries of the soil. Excellent news indeed.
Surely it is time to honor the soil bacteria with little drawings of their habitats alongside the barcodes?
Nature News has an interesting commentary by Heidi Ledford, with photos, interviews, links, and technical details.